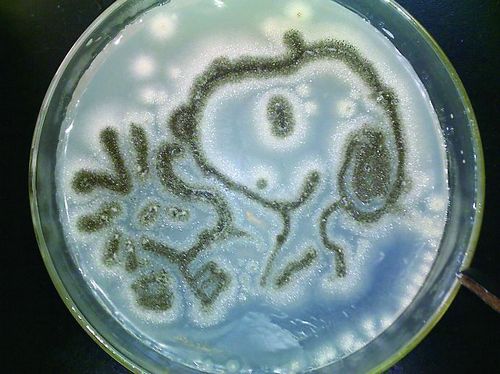

2011年5月22日,由中国海洋大学举办的 “绚丽生命”趣味生物现象DIY大赛落下帷幕。大赛面向全省多所高校,“百奥”微生物团队代表我校受邀参赛,其作品力挫群雄,荣获微生物作画金奖。
“绚丽生命”趣味生物现象DIY大赛是中国海洋大学大学生科技文化艺术节系列活动之一,来自哈尔滨工业大学(威海分校)、山东科技大学、中国海洋大学、山东农业大学等多所高校的代表队伍参赛。经评委会综合评审,代表山东农业大学参赛的“百奥”微生物队以其独特新颖的创意、扎实稳进的实力,战胜多所高校,摘得微生物作画金奖,同时获得300倍数码显微摄像仪一台、海洋珍稀标本4件。
评委会给予“百奥”微生物团队作品评价是:“百奥微生物队独具匠心地选取黑曲霉与四联球菌组合,同时利用霉菌与细菌黑、黄、白三种色彩同时培养,为我们创造了银光闪闪的史努比形象与亦真亦幻的雪花喷涂效果。该团队成员通力协作,克服并利用了黑曲霉作画色彩范围控制的不确定性。四联球菌色彩艳丽,与黑曲霉营养菌丝营造出了完美的创意构想。”
“百奥”微生物团队荣誉的取得源于生科学院对科技创新的高度重视和大力投入。学院开放实验室,鼓励学生积极参与实验与交流,提高创新实践操作等综合能力。并通过特色学术社团开展了一系列亮点突出、特色鲜明的活动,综合培养了学生的理论与实践的结合能力,理论付诸实践的应用能力,理论联系实践的应用能力。
“百奥”微生物科技协会作为省级优秀社团,成员们积极申报大学生科技创新项目,现有国家级SRT项目2项,校级SRT项目17项,泰安市科技创新引导计划项目4项,已在《微生物学杂志》、《微生物学通报》、《菌物学报》等期刊发表论文多篇。